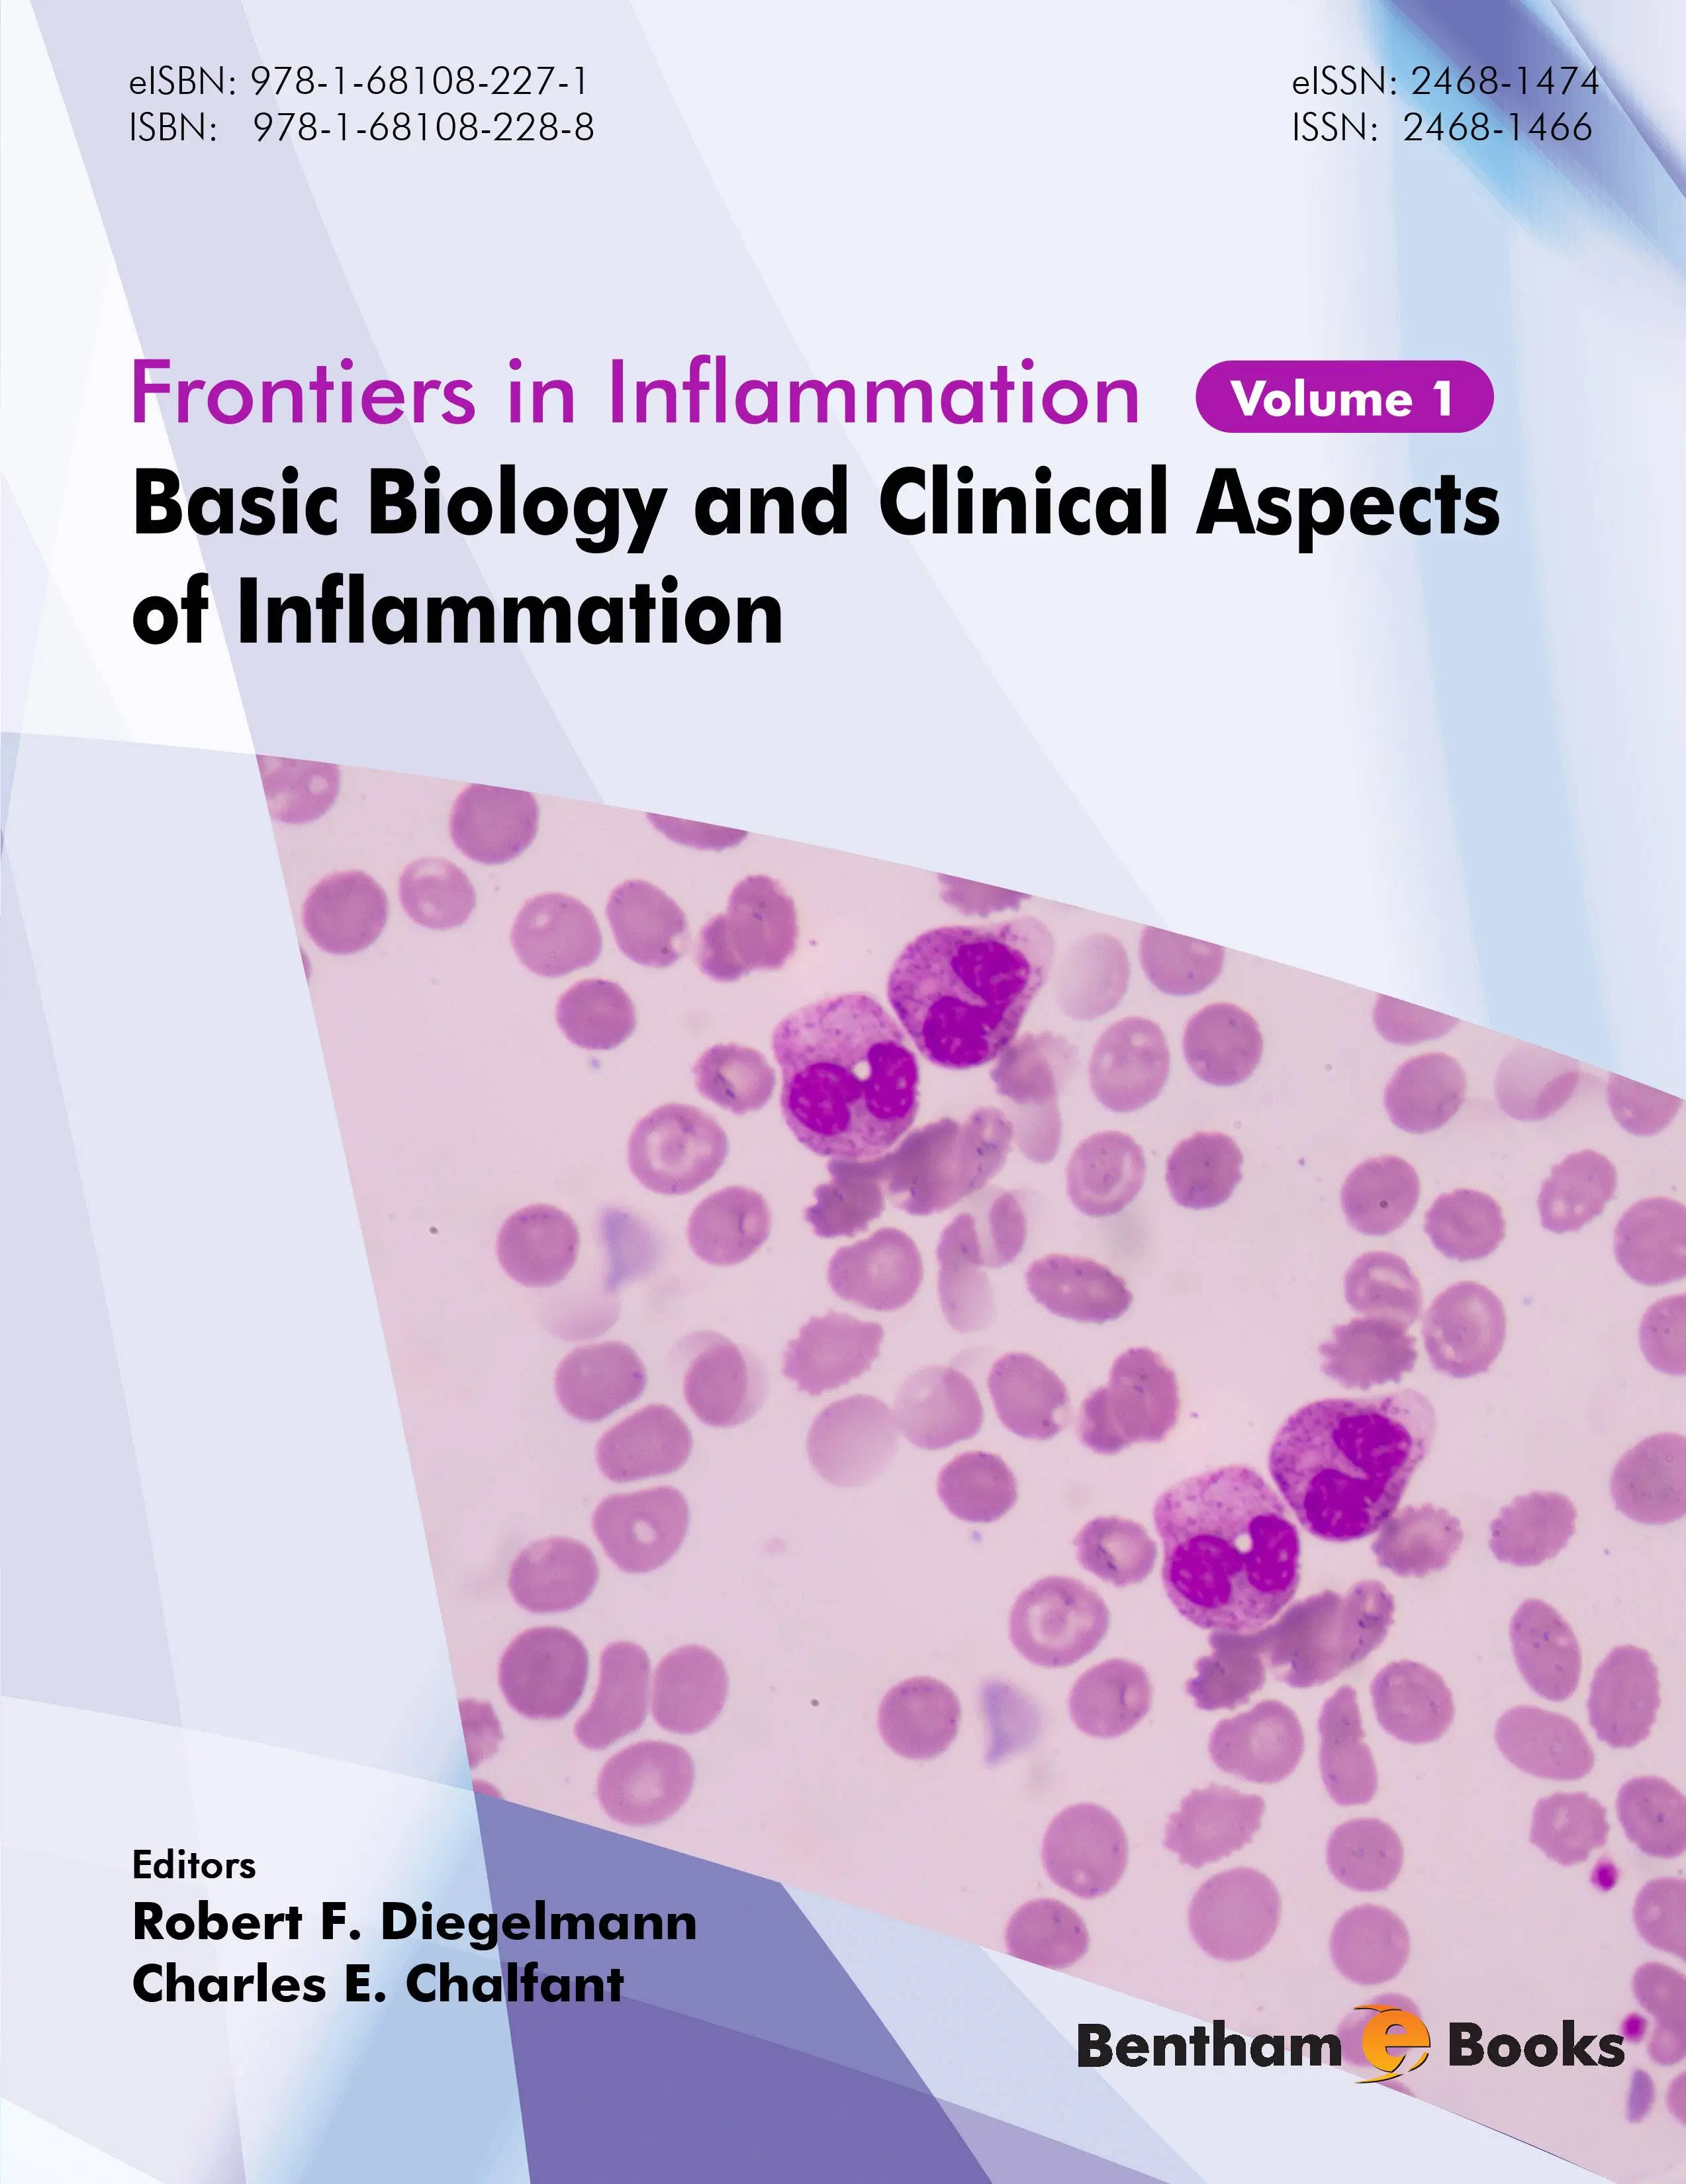

Basic Biology and Clinical Aspects of Inflammation
Bentham | English | 2016 | ISBN-10: 1681082284 | 494 pages | PDF | 7.56 mb
Bentham | English | 2016 | ISBN-10: 1681082284 | 494 pages | PDF | 7.56 mb
By Robert F. Diegelmann, Charles E. Chalfant
Basic Biology and Clinical Aspects of Inflammation provides information about the critical cells and biochemical mediators involved in the complex process of inflammation. Readers are introduced to the basic scientific background on the subject, after which the book progresses towards translational research in clinical settings. Topics covered in this volume include, the modulation of inflammation during normal and chronic wound healing, altered metabolism during inflammation processes, the effect of ageing on inflammatory processes, as well as details about the underlying molecular processes behind specific clinical pathologies that are driven by excessive inflammation in the body (allergic reactions, type 2 diabetes, cardiac and vascular disease, arthritis, periodontal disease, inflammatory bowel disease and neuroinflammation). The volume also provides the latest information on pharmacotherapy for inflammation and interesting contributions towards the mathematical modeling and network analysis of inflammation. Basic Biology and Clinical Aspects of Inflammation features contributions from by a distinguished group of international researchers and clinicians highly recognized for their specific expertise in the field of inflammation. The information presented in this reference is useful to academics, medical professionals, health care regulators and pharmaceutical scientists.
Feel Free to contact me for book requests, informations or feedbacks.